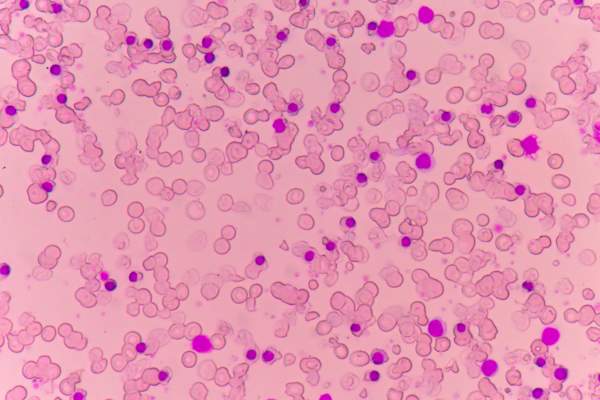
显微镜下贫血患者的血涂片

10个令人惊讶的事实关于溃疡性结肠炎


希波克拉底说:“所有的疾病在肠道中开始了。”大约2000年后,主流科学终于同意:细菌你的胃肠系统内的一个糟糕的组合已被证实与自身免疫性疾病,精神健康状况,心脏疾病,甚至某些癌症。因此,它与溃疡性结肠炎(UC),它破坏了肠道微生物和触发免疫系统攻击结肠衬里细胞,导致激烈而痛苦的症状。
但是希波克拉底并不知道内脏相关疾病的所有信息:无论你是否患有UC,我们发现了一些关于这种疾病的令人惊讶的信息,你真的应该知道。

#1:这是较为普遍比以往
溃疡性结肠炎影响了70多万美国人,自2011年以来增加了15%。一些研究人员认为,西方的饮食习惯和久坐的生活方式是造成肥胖的部分原因。虽然它可以影响任何年龄层,“它通常开始于青少年或年轻人,”胃肠病学家、医学博士、西北医学消化健康中心的医学主任Stephen B. Hanauer说。根据美国克罗恩病和结肠炎基金会(CCFA)的数据,大多数UC患者在35岁之前就被确诊了。据估计,有15%到20%的UC患者是儿童。

#2:这是遗传,但大多数人并不有家族史
这里的遗传成分:一个人继承从夫妻店的风险。但是,对于UC实际表现“就需要遗传缺陷的特定组合,”加勒特劳勒,医学博士,在纽约长老会医院在纽约市的炎症性肠病计划的副主任。
这意味着,奇怪的是,那谁拥有UC大多数人都没有与它的家庭成员。“他们的父母的基因,但不发病,”劳勒博士说。有160个与炎症性肠病研究人员正试图链接UC相关的基因。

#3:这可能是由感染引发
你的身体不发展心血来潮溃疡性结肠炎。首先,你必须携带该基因,这使你的免疫系统易受高速模式。但是,如果它与一个特定的触发,这是每个人不同的接触只能发生。“这可能是在环境的感染或什么的,”劳勒博士说。“我们还不能确定。”
细菌感染,如大肠杆菌,已经被研究作为UC的潜在原因。虽然研究人员没有发现吸烟的细菌,只是还没有,这个理论是说免疫系统反应过度入侵者,而是冒号的攻击,导致炎症和溃疡。

你可能首先在关节处感觉到它
斯蒂芬B.哈诺尔,医学博士,西北大学医学院在芝加哥的消化系统健康中心的医疗主任说,结肠的炎症实际上会导致整个身体的其他部位的炎症反应。这包括关节肿胀和疼痛的潜力,这通常是在胃肠道EASES消失,一旦炎症。事实上,关节炎是最常见的并发症,最多的人与UC体验这30%中的一个。

维生素缺乏是一种症状
劳勒博士说,造成这种情况的原因有两个:1)因为腹泻是UC最常见的症状之一——炎症会阻止结肠吸收水分,导致排便——人体难以充分吸收健康生活所需的营养。“病人有时会脱水或出现某些维生素和元素的缺乏,尤其是维生素D和铁,”他补充道。2)所有这些腹泻可导致体重迅速下降,这意味着你得到的营养物质,你输了。
#7:它可以让你贫血
UC可以吮吸,但它不会说谎:正如它的名字,溃疡性结肠炎的特征是结肠溃疡,“这可能会导致出血,”哈诺尔博士说。这就是为什么贫血可出现。“从结肠慢性失血可导致缺铁性贫血,”哈诺尔博士说。贫血的人缺乏足够的红细胞携带氧的整个身体,使他们感到疲倦和虚弱。

#8:你会觉得像你必须船尾......但不能
“溃疡性结肠炎,直肠不能放松,创造了不断需要撤离的感觉,”哈诺尔博士说。这一切都太经常“我得走了现在”感觉被称为里急后重,这是烦人,因为就像你尝试和应变,往往会有什么(或很少)留下您的大肠排空。

你可能会和抑郁做斗争
“情绪低落是很常见的抑郁症溃疡性结肠炎,”劳勒博士说。“也许这是关系到对社会生活,工作能力,或肠道疾病甚至是耻辱,有时仍会发生疾病影响的负担。”
那些患有UC的人甚至在确诊之前就已经被发现有更高的抑郁率。发表在《自然》杂志上的一项研究加拿大胃肠病学和肝病学杂志这表明抑郁可能是对无症状的、未确诊的肠道疾病的反应,但需要更多的研究来充分理解两者之间的联系。

它会增加你患结肠癌的风险
就像慢性炎症可引起其他器官的癌症(吸烟和肺癌,肝炎和肝癌;晒斑和皮肤癌),溃疡性结肠炎不受控制的炎症与结肠癌的风险增加有关,哈诺尔博士解释说。虽然所有结肠癌病例仅1%至2%是由UC引起的,它占死亡在那些与UC的10%至15%。